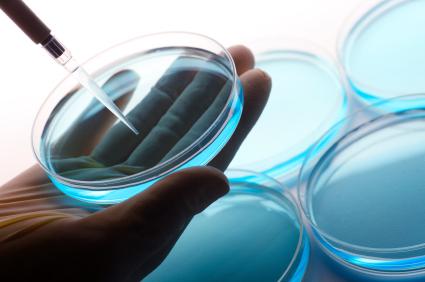

قال علماء من كلية الطب بجامعة هارفارد، إنهم نجحوا في تجربة تماثل العمل على تجديد عمر عضلات إنسان في عمر الستين وإعادتها لما كانت عليه في عمر العشرين.
و تمكن العلماء من إعادة الشباب في أنسجة (فئران تجارب) تقدمت بالسن بعد زيادة معدلات مادة كيميائية يطلقُ عليها اسم (إن إيه دي).
BBC